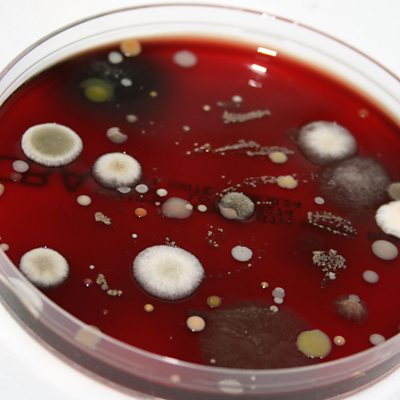

Episode details

Available for over a year
A bheil feum unnt no an e cron a tha iad a’ dèanamh? An dotair Alasdair MacCoinnich.
Programme WebsiteUse ГЫСїґ«ГЅ.com or the new ГЫСїґ«ГЅ App to listen to ГЫСїґ«ГЅ podcasts, Radio 4 and the World Service outside the UK.
Available for over a year
A bheil feum unnt no an e cron a tha iad a’ dèanamh? An dotair Alasdair MacCoinnich.
Programme Website